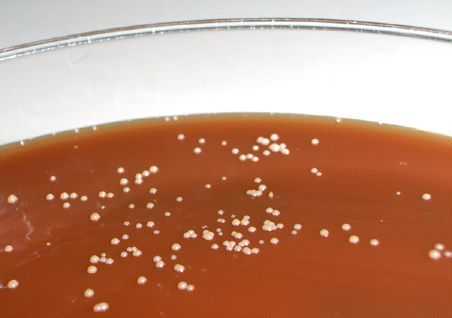
Колонии стрептобацилл на питательной среде

Шанкроид - причины, симптомы, диагностика и лечение
Добавил пользователь Alex Обновлено: 01.02.2026
Шанкроид (а также - мягкий шанкр, венерическая язва, третья венерическая болезнь) - это острая венерическая инфекция, которая проявляется болезненными множественными язвами половых органов и воспалением лимфатических узлов.
Шанкроид является эндемичным заболеванием для стран Африки, Юго-Восточной Азии, Центральной и Южной Америки, а в некоторых регионах заболевание преобладает над сифилисом. Шанкроид регистрируется в Великобритании, Португалии, Италии, США и других странах. В США ежегодно сообщается не менее чем о 1000 случаев заболевания. Во многих крупных городах Соединенных Штатов шанкроид стал эндемичным заболеванием; при этом широко распространена неполная регистрация этой инфекции. В странах бывшего Советского Союза шанкроид встречается редко, в основном заражение происходит во время поездок за рубеж.
Что провоцирует / Причины Шанкроида (мягкого шанкра):
Возбудителем мягкого шанкра является палочка мягкого шанкра Haemophilus ducreyi. Впервые палочка мягкого шанкра была описана в 1887 году русским ученым О. В. Петерсеном. В 1889-1892 годах ее подробно изучали итальянский дерматолог А. Дюкрёй и немецкий дерматолог П. Г. Унна. По имени этих трех ученых-исследователей палочка мягкого шанкра получила свое второе название - стрептобацилла Дюкрея-Унны-Петерсена.
Палочки мягкого шанкра располагаются в очаге поражения довольно характерным образом: параллельными рядами. Исследователи сравнивают расположение палочек мягкого шанкра в мазке гноя с «цепочками» или же «стайками рыб». Сами стрептобациллы имеют закругленные концы и перетяжку в середине, их длина составляет 1,5-2 мкм, а толщина 0,4-0,5 мкм. Заражение мягким шанкром происходит, как правило, во время полового контакта, когда стрептобациллы попадают либо на поврежденную кожу, либо на слизистую оболочку половых органов.
Палочки мягкого шанкра хорошо переносят низкие температуры, к различным химическим веществам они тоже достаточно устойчивы. Однако при температуре выше 40°С стрептобацилла погибает.
Патогенез (что происходит?) во время Шанкроида (мягкого шанкра):
Основной путь передачи шанкроида (мягкого шанкра, венерической язвы), как и всех венерических заболеваний - половой. Заражение может произойти при любом виде полового контакта: как генитальном, так и оральном и анальном. Если один из половых партнеров болен мягким шанкром, то риск передачи инфекции довольно высок. Специалисты считают, что вероятность заражения при единичном половом контакте без презерватива с больным мягким шанкром партнером составляет примерно 50%.
Мягкий шанкр в равной степени поражает мужчин и женщин, однако, случаи скрытого бациллоносительства описаны по большей части у женщин. Такая женщина может заражать своих партнеров, но у нее самой болезнь никак не проявляется, и больная может даже не знать о том, что является носителем столь экзотического заболевания, как мягкий шанкр.
Что касается других путей заражения мягким шанкром, то они встречаются настолько редко, что многие специалисты склоняются к тому, чтобы считать случаи бытового заражения мягким шанкром недоказанными случаями заражения при половом контакте.
Симптомы Шанкроида (мягкого шанкра):
Как и большинство венерических заболеваний, мягкий шанкр (он же шанкроид, или венерическая язва) имеет инкубационный период. Инкубационный период мягкого шанкра длится, как правило, недолго: 3-5 суток у мужчин и до 10 дней у женщин. Иногда он может продлиться дольше, до нескольких недель, но это редкость. Иногда инкубационный период мягкого шанкра, напротив, укорачивается до 2 или даже 1 дня.
После окончания инкубационного периода на месте внедрения возбудителя - стрептобациллы появляется небольшое отечное пятно ярко-красного цвета, в его центре вскоре образуется узелок, на месте которого вскоре возникает пузырек с гнойным содержимым. Через несколько дней пузырек вскрывается, и на его месте образуется сам шанкр - болезненная язва диаметром от нескольких миллиметров до нескольких сантиметров и неправильной формы.
Образовавшееся на месте внедрения возбудителя изъязвление быстро разрастается, увеличиваясь и в диаметре (до 1-1,5 см), и в глубину. Язва при мягком шанкре кровоточива и резко болезненна, что отличает ее от твердого шанкра, возникающего при сифилисе. Основание язвы и она сама мягкие на ощупь (отсюда и название болезни «мягкий шанкр»), неровные края язвы окружены отечным воспалительным венчиком, дно покрыто гнойно-кровянистым налетом. Попадая на окружающие ткани, это гнойное отделяемое провоцирует образование новых множественных изъязвлений, меньшего размера, так что одиночные язвы при мягком шанкре встречаются редко. Новые мелкие язвы обычно располагаются по периферии вокруг большой язвы. Сливаясь, они образуют новую большую, как бы «ползущую» язву. Чаще всего при шанкроиде одновременно бывает много язв, которые находятся в разных стадиях развития.
Чаще всего первичные шанкры (язвы) при мягком шанкре образуются в области половых органов:
- на внутреннем листке крайней плоти
- в венечной борозде
- на уздечке полового члена
- губках мочеиспускательного канала
- в ладьевидной ямке
- на больших и малых половых губах
Но возможны и другие варианты их локализации - так называемые, первичные внеполовые проявления мягкого шанкра (то есть проявления, возникающие вне половых органов).
Их расположение зависит, прежде всего, от того, при каких обстоятельствах произошло заражение мягким шанкром. Иногда, правда, довольно редко, язва образуется в области ануса (здесь она представляет собой глубокую болезненную трещину), еще реже - на слизистой рта, если заражение произошло при анальном или оральном половом контакте. Кроме того, были описаны случаи возникновения первичных внеполовых проявлений венерической язвы в связи с профессиональной деятельностью у медицинских работников. В подобном случае изъязвления, вызванные мягким шанкром, могут располагаться на кистях или пальцах рук.
Кроме первичных внеполовых проявлений возможно образование вторичных внеполовых проявлений мягкого шанкра. Такие шанкры возникают при затекании гнойного отделяемого первичной язвы на близлежащие участки кожи внутренней поверхности бедер или на отдаленные от половых органов участки тела. Чаще всего «виноваты» в появлении вторичных шанкров сами больные, которые в прямом смысле слова собственными руками переносят инфекцию с пораженных половых органов на другие области тела.
Процесс образования шанкров (язв) продолжается, как правило, 2-4 недели, после чего дно язвы очищается, и еще через некоторое время происходит заживление с образованием небольшого рубца. В неосложненных случаях заживление наступает через 1-2 мес. после заражения, если же течение мягкого шанкра было осложнено, то времени на заживление язв требуется больше. При отсутствии же полноценного лечения мягкого шанкра следующей ступенью мягкого шанкра становится поражение лимфатических узлов и сосудов, которое приводит к многочисленным осложнениям.
Иногда способность мягкого шанкра к периферическому росту приобретает выраженный характер, при этом возникает так называемый серпигинозный мягкий шанкр. Его особенностью является то, что язва, рубцуясь в центре, распространяется с половых органов на лобок, бедра, промежностьи область ануса.
Язва при мягком шанкре может распространяться не только по периферии, но и вглубь. При таком разрастании язвы может возникнуть гангренозная разновидность мягкого шанкра, которая считается наиболее тяжелой и чреватой особенно опасными осложнениями.
При гангренозной разновидности мягкого шанкра язва проникает в глубину, обнажая кавернозные тела. У больного появляется озноб, повышается температура тела, развиваются септические явления; иногда происходит разрушение кавернозных тел, которое сопровождается сильным кровотечением. В некоторых случаях гангренозный процесс приобретает длительное прогрессирующее течение, поражая обширные участки кожи. В этом случае речь идет о фагеденическом мягком шанкре.
На начальном этапе развития мягкого шанкра полное излечение больного затруднения не представляет. Разумеется, проводить лечение должен только врач-венеролог. При отсутствии серьезных осложнений и запущенной болезни излечение наступает в течение 7-10 дней. Однако иммунитета к мягкому шанкру организм человека не вырабатывает, поэтому повторное заражение остается возможным.
Осложнения шанкроида
Чаще всего встречаются: лимфангиит (воспаление лимфатических протоков), лимфаденит (воспаление лимфоузлов), фимоз (сужение отверстия крайней плоти), парафимоз (ущемление головки полового члена суженной крайней плотью).
Лимфангиит наблюдается на спинке полового члена и на наружной поверхности половых губ. Проявляется в виде уплотненного болезненного тяжа. Кожа над утолщенной поверхностью гиперемирована и отечна, пальпация болезненна. В редких случаях по ходу болезненного тяжа возникают воспалительные узлы, которые могут нагнаиваться, а затем превращаться в бубонули (шанкры Нисбета).
Наиболее типичным признаком шанкроида является регионарный лимфаденит (бубон) , возникающий через 2-3 недели после заражения. Лимфаденит характеризуется остро возникающим односторонним увеличением одного или нескольких лимфатических узлов, спаянных между собой и с кожей. Над пораженными лимфатическими узлами кожа приобретает ярко-красный цвет. Воспаление лимфоузлов может через некоторое время пройти самостоятельно, образовавшийся бубон при этом рассасывается. Возможно нагноение: в центре бубона появляется флюктуация, и он вскрывается с выделением густого гноя с примесью крови. Образующаяся при этом язва впоследствии рубцуется.
Когда имеется отек крайней плоти, может развиться фимоз. При этом головку полового члена обнажить не удается, а скапливающийся под крайней плотью гной выделяется через узкое препуциальное отверстие. В гнойном отделяемом обнаруживают возбудителей шанкроида.
При отеке крайней плоти, находящейся за обнаженной головкой полового члена, возможен парафимоз. Его исходом может быть гангрена головки полового члена вследствие сдавливания тканей кольцом отечной крайней плоти.
Диагностика Шанкроида (мягкого шанкра):
Лабораторная диагностика шанкроида
Исследуют язвенные поражения и гнойное отделяемое вскрывшихся или невскрывшихся лимфатических узлов.
1. При микроскопии окрашенных препаратов видны ряды цепочек грамотрицательных мелких палочек, расположенных в виде «стаи рыб» между лейкоцитами. Такое расположение микроба, его характерная окраска, отсутствие другой флоры говорят о наличии возбудителя шанкроида.
2. В сомнительных случаях можно использовать специальные методы выделения возбудителя с помощью культуры тканей.
3. Иногда проводят аутоинокуляционную пробу: материал, взятый из язвы, вносится в царапину на животе или бедре самого пациента. Сверху пластырем наклеивается часовое стеклышко, позволяющее наблюдать за ходом развития пробы. В течение 1-3 суток развивается типичный шанкроид, в котором могут быть обнаружены его возбудители. В настоящее время аутоинокуляционная проба существенного значения не имеет, так как при подозрении на шанкроид начинают лечение антибиотиками.
4. Современная диагностика шанкроида включает методику полимеразной цепной реакции (ПЦР).
Лечение Шанкроида (мягкого шанкра):
Как правило, мягкий шанкр достаточно легко и полностью излечивается при помощи антибиотиков или сульфаниламидных препаратов. Чаще всего используются антибиотики, действие которых направлено на уничтожение не только стрептобацилл, но и бледных трепонем - возбудителей сифилиса.
Курс лечения венерической язвы обычно составляет 1-2 недели, после чего пациент в течение полугода должен профилактически посещать врача для того, чтобы избежать рецидивов и развития других инфекций, наиболее опасной из которых является сифилис.
Кроме антибиотиков общего действия при лечении мягкого шанкра используются местные антибиотики, как правило, в виде мазей, которые помогают устранить клинические симптомы мягкого шанкра, причиняющие пациенту боль и неудобства.
Кроме того, в лечении мягкого шанкра в качестве дополняющих основное лечение средств используются общеукрепляющие и иммуномодулирующие препараты.
Если же больной обращается к венерологу с запущенной формой мягкого шанкра, которая успела дать осложнения, то иногда врачу приходится прибегать к хирургическому вмешательству. Поэтому лечение мягкого шанкра необходимо начинать на как можно более ранней стадии заболевания.
Профилактика Шанкроида (мягкого шанкра):
К каким докторам следует обращаться если у Вас Шанкроид (мягкий шанкр):
Вас что-то беспокоит? Вы хотите узнать более детальную информацию о Шанкроида (мягкого шанкра), ее причинах, симптомах, методах лечения и профилактики, ходе течения болезни и соблюдении диеты после нее? Или же Вам необходим осмотр? Вы можете записаться на прием к доктору .
Первичный сифилис
Первичный сифилис — первая стадия сифилиса, возникающая после заражения бледной трепонемой и начинающаяся с кожных проявлений в месте ее внедрения. Характеризуется появлением твердого шанкра (первичной сифиломы) на коже или слизистой с последующим развитием регионарного лимфангита и лимфаденита. При локализации элементов первичного сифилиса на коже полового члена возможно развитие баланопостита, фимоза, гангренизации и других осложнений. Диагноз первичного сифилиса устанавливается на основании анамнеза, обнаружения твердого шанкра и выявлении в его отделяемом бледных трепонем, положительных результатов серологических исследований, ПЦР-диагностики. Лечение осуществляется препаратами пенициллина.
Общие сведения
Современная венерология отмечает некоторые отличия в клинической картине первичного сифилиса по сравнению с теми его проявлениями, которые наблюдались ранее. Если раньше у 90% заболевших первичным сифилисом твердый шанкр носил одиночный характер, то сейчас возросло число случаев появления сразу 2-х и более шанкров. Отмечается существенное увеличение язвенных форм твердого шанкра и форм первичного сифилиса, осложненных пиодермией. Вырос удельный вес твердых шанкров, расположенных на слизистой рта и в области ануса.
Классификация первичного сифилиса
- Первичный серопозитивный сифилис — сопровождается положительными серологическими реакциями на сифилис.
- Первичный серонегативный сифилис — у пациента серологические исследования дают отрицательный результат.
- Скрытый первичный сифилис — протекает с отсутствием клинических проявлений заболевания, может быть серопозитивным и серонегативным. Эта форма сифилиса чаще наблюдается у пациентов, которые начали лечение на ранних стадиях, но не закончили его.
Симптомы первичного сифилиса
Клинические проявления первичного сифилиса возникают спустя 10-90 дней от момента заражения пациента. Место появления первичной сифиломы, называемой твердым шанкром, соответствует месту внедрения бледной трепонемы через кожные покровы или слизистую оболочку. Как правило, это половые органы: у мужчин чаще всего головка полового члена и крайняя плоть, у женщин — половые губы, слизистая влагалища и шейки матки. Последнее время при первичном сифилисе все чаще встречается экстрагенитальное (внеполовое) расположение шанкра: на коже и слизистой ануса, животе, бедрах, лобке, пальцах рук, слизистой губ, языка и ротовой полости.
Твердый шанкр первичного сифилиса представляет собой округлую мясисто-красную эрозию диаметром до 1 см. Приподнятые края эрозии придают ей блюдцеобразный вид, а скудное серозное отделяемое делает ее поверхность как бы лакированной. Свое название твердый шанкр получил благодаря плотному инфильтрату, лежащему в основании эрозии. Однако современные венерологи отмечают в своей практике случаи шанкров без выраженного уплотнения в основании. Обычно первичный сифилис протекает без субъективных ощущений, большинство пациентов отмечает лишь незначительную болезненность в области шанкра. Разрешение эрозивного шанкра происходит, не оставляя на коже или слизистой никаких следов. В тоже время при первичном сифилисе встречаются язвенные формы твердого шанкра с более выраженными краями и уплотнением основания. Их заживление происходит с образование рубца.
Первичный сифилис может протекать с появлением атипичных форм твердого шанкра, что встречается относительно редко. К атипичным формам относят: индуративный отек, шанкр-амигдалит и шанкр-панариций. Индуративный отек встречается в области мошонки, крайней плоти и больших половых губ. Его плотность настолько велика, что надавливание пальцем в месте отека не оставляет после себя углубления. Первичный сифилис в виде шанкра-амигдалита проявляется односторонним безболезненным увеличением и уплотнением миндалины, сопровождающимся ее окрашиванием в красно-медный цвет. Отсутствие выраженных воспалительных изменений, болезненности и температурной реакции позволяет отличить эту форму первичного сифилиса от ангины или обострения хронического тонзиллита.
Шанкр-панариций имеет место чаще всего при развитии первичного сифилиса у медицинских работников (гинекологи, урологи, стоматологи, лаборанты и пр.). Он характеризуется резкой болезненностью, уплотнением и вздутием концевой фаланги одного из пальцев руки. Предположить первичный сифилис в таких случаях помогает отсутствие выраженного покраснения и наличие плотной инфильтрации пораженной области. Заподозрить первичный сифилис при всех атипичных формах твердого шанкра можно по типичному для сифилиса выраженному увеличению регионарных лимфоузлов: паховых при индуративном отеке, шейных и поднижнечелюстных при шанкре-амигдалите, локтевых при шанкре-панариции.
Осложнения первичного сифилиса
Наиболее часто первичный сифилис осложняется вторичной бактериальной или трихомонадной инфекцией с развитием баланита или баланопостита. Последний может приводить к сужению крайней плоти с возникновением фимоза. Если при этом твердый шанкр локализуется в венечной борозде, то его обследование становится невозможным, что затрудняет диагностику первичного сифилиса. Попытки пациента самостоятельно открыть головку могут привести к ее ущемлению и возникновению парафимоза.
Более редким осложнения первичного сифилиса является гангренизация, обусловленная фузоспириллезной инфекцией. При этом твердый шанкр покрывается черным струпом. Распространение процесса за пределы шанкра говорит о развитии фагеденизма.
Диагностика первичного сифилиса
С проявлениями первичного сифилиса в своей практике сталкивается не только врач-венеролог, но и андролог, уролог, гинеколог, дерматолог, отоларинголог, проктолог, стоматолог. Выявление твердого шанкра и наличия в анамнезе пациента сведений о половом контакте, который мог быть причиной заражения, является основным моментом на начальном этапе диагностики первичного сифилиса. Затем проводится исследование отделяемого шанкра для обнаружения бледной трепонемы. Вспомогательным методом является исследование на бледные трепонемы пунктата, взятого в ходе биопсии лимфатического узла. Серологические реакции (РИФ, РИБТ, RPR-тест) становятся положительными лишь спустя 3-4 недели от начала проявлений первичного сифилиса. Поэтому в ранний период первичного сифилиса применяется ПЦР-диагностика.
Дифференциальная диагностика первичного сифилиса проводится с генитальным герпесом, трихомониазом, гонореей, чесоткой, псориазом, баланопоститом, болезнью Кейра, эрозией шейки матки, раком вульвы и другими заболеваниями. При расположении твердого шанкра на губах первичный сифилис необходимо дифференцировать от хейлита и простого герпеса, при его локализации на слизистой рта — от стоматита, пузырчатки, язвенной формы милиарного туберкулеза, раковой язвы, поражений слизистой при красном плоском лишае, системной красной волчанке, лейкоплакии.
Лечение первичного сифилиса
Терапия первичного сифилиса проводится препаратами пенициллинового ряда. Осуществляют внутримышечное введение водорастворимого пенициллина каждые 3 часа, новокаиновой соли бензилпенициллина дважды в сутки или комбинированных препаратов бензилпенициллина по схеме. Дозы и длительность лечения зависят от формы первичного сифилиса. Важное значение имеет обследование и лечение половых партнеров больного.
У пациентов с аллергией на пенициллин лечение первичного сифилиса может проводиться доксициклином или тетрациклином. Некоторые исследования указывают на эффективность цефтриаксона в лечении первичного и вторичного сифилиса. Однако малое число таких наблюдений дает недостаточное количество информации для установления его оптимальных доз и наиболее целесообразной продолжительности лечения.
После проведенного лечения пациенты с серонегативным первичным сифилисом в течение года находятся на обязательном диспансерном наблюдении, а пациенты с серопозитивным первичным сифилисом — три года. Контроль излеченности осуществляется на протяжении всего периода диспансерного наблюдения путем проведения RPR-теста. Сохранение резко положительных результатов теста в течение года является показанием к дополнительному лечению.
Шанкроид
Шанкроид - это инфекционная болезнь, передаваемая половым путем, реже ‒ при контактно-бытовых взаимодействиях. Патогномоничными симптомами считаются болезненные, мягкие генитальные либо экстрагенитальные язвы, а также поражение регионарных лимфатических узлов. Диагностическими методами обнаружения возбудителя являются бактериоскопические, культуральные, молекулярно-генетические исследования. Лечебные мероприятия при шанкроиде сводятся к назначению антибактериальных средств в качестве этиотропной терапии, патогенетическому и симптоматическому лечению.
МКБ-10

Шанкроид (венерическая язва, мягкий шанкр, третья венерическая болезнь) является бактериальной инфекцией. Впервые описание заболевания в 1887 году сделал русский ученый О. Петерсон, более детальное описание мягкого шанкра принадлежит дерматологам А. Дюкрею и П. Унна (1889-1892 гг.). Широкое распространение инфекция получила в странах Азии, Африки, Латинской Америки; в Европе и США регистрируются завозные случаи. Преимущественно поражаются мужчины, женщины выступают, скорее, как бессимптомные носители. Доказано, что заражение шанкроидом увеличивает риск инфицирования ВИЧ.
Причины шанкроида
Возбудитель заболевания - бактерия Haemophilus ducreyi (палочка Дюкрея). Источником инфекционных агентов служит больной человек, либо носитель. Пути передачи - половой (все виды сексуальных контактов), контактно-бытовой, реализуемый обычно в неблагополучных условиях проживания. Дополнительно может происходить аутоинфицирование у лиц с бессимптомным течением при несоблюдении правил интимной гигиены, отказе от лечения.
Высокой вероятности заражения подвержены гомосексуалисты, коммерческие секс-работники, беременные, дети из неблагополучных семей. Основные факторы риска шанкроида:
- случайные половые контакты без использования барьерной контрацепции
- необрезанная крайняя плоть у мужчин
- сопутствующие симптомы инфекции гениталий
- аллергические реакции на коже или слизистых
- местный прием лекарственных средств, вызывающих раздражение покровов.
Патогенез
При попадании на кожу либо слизистую возбудитель проникает внутрь фибробластов и кератиноцитов, может образовывать внеклеточные колонии. Благодаря поверхностным белкам и вырабатываемым факторам патогенности бактерии привлекают в очаг В-, Т-лимфоциты, способствуя их апоптозу. Во время процесса развития образуется гранулематозный инфильтрат из возбудителей и лейкоцитарных масс, который со временем превращается в язвенный дефект.
Распространяясь лимфогенным путем, бактерии проникают в региональные лимфоузлы, обычно паховые. Развивается периаденит, лимфатические узлы спаиваются между собой. Основание язвы представлено некрозом с периваскулярным инфильтратом из полиморфно-ядерных лейкоцитов, эритроцитов, фибрина. Расположенный глубже инфильтрат состоит из плазматических клеток и вновь образованных кровеносных сосудов с пролиферацией эндотелия, микротромбами.
Симптомы шанкроида
Инкубационный период отличается среди полов: у мужчин занимает около 7-10 суток, у женщин - до трех недель. Сроки отсутствия симптомов могут сокращаться, если имеется иммунный дефицит любой природы, повреждение покровного аппарата. Чаще всего шанкр находится на половых органах, но может обнаруживаться в промежности, на внутренней поверхности бедер, анусе, перианальной области, конечностях, губах, груди и веках. Элементов может быть несколько.
Первым сигналом служит появление розоватого пятна и отека, небольшого увеличения и чувствительности регионарных лимфоузлов. Интоксикационные симптомы минимальны, лихорадка отсутствует. Через несколько дней на месте пятна появляется болезненный узелок, превращающийся в гнойный пузырек, после вскрытия которого образуется резко болезненная язва с высокими краями и гнойным отделяемым (мягкий шанкр). При пальпации образование резко болезненно.
В зависимости от локализации симптомы шанкроида могут включать боли при мочеиспускании, дефекации, половых контактах, отечность половых губ и мошонки. Нередкое гнойное воспаление паховых лимфоузлов сопровождается их увеличением, появлением спаянных конгломератов, синюшностью кожи и резкой болезненностью, ознобами, лихорадкой. Иногда возникает обширное разрушение тканей полового члена с высокой вероятностью самоампутации.
Осложнения
Частое осложнение шанкроида - симптомы гнойного воспаления лимфатических узлов (лимфаденит) или сосудов (лимфангиит). Нередко происходит образование свищей с выделением некротизированных масс. При сильном отеке крайней плоти у мужчин возникает фимоз, при котором невозможно освобождение головки пениса и излитие гноя. Сдавление головки отечной крайней плотью - парафимоз - при продолжительном течении вызывает гангрену.
Присоединение иной бактериальной флоры приводит к появлению симптомов уретрита, баланита, баланопостита. В случае длительного периода нелеченного шанкроида восходящее инфицирование палочкой Дюкрея совместно с другими патологическими агентами способно вызывать цистит и пиелонефрит. У беременных женщин возможно преждевременное начало родовой деятельности, если шанкр расположен во влагалище, на шейке матки.
Диагностика
Диагностика и лечение шанкроида преимущественно осуществляется дерматовенерологами. Врачи других специальностей привлекаются при наличии показаний. Обязательно обследование всех половых партнеров больного, особенно при имеющихся незащищенных сексуальных контактах, а также лиц, проживающих вместе с пациентом. Основные лабораторно-инструментальные и клинические данные патологии:
- Физикальное обследование. При объективном осмотре общее состояние обычно не изменено. Наиболее частой локализацией шанкра у мужчин являются крайняя плоть, мошонка, венечная борозда, ствол и головка полового члена, у женщин - преддверие влагалища, половые губы, клитор. Элемент представляет собой мягкую, болезненную язву округлой формы, с подрытыми мягкими краями, узким эритематозным ободком по периферии, дно - с некротическим зловонным экссудатом.
- Лабораторные исследования. Присоединение уретрита или гнойного лимфаденита демонстрирует лейкоцитоз, сдвиг формулы влево, ускорение СОЭ, лейкоцитурию и эритроцитурию в общеклинических пробах, рост концентрации СРБ при биохимическом тесте. При подозрении на шанкроид рекомендуется проведение анализа крови на наличие антител к ВИЧ, возбудителю сифилиса, а также ПЦР-исследования на вирус генитального герпеса.
- Выявление инфекционных агентов. Проводится бактериоскопический анализ язвенного содержимого, посев биологического субстрата на питательные среды. Наиболее точный и быстрый результат обнаруживается при ПЦР-диагностике. Серологические методы малоинформативны из-за возможных перекрестных реакций с другими бактериями семейства Haemophilus. Гистологическое исследование биоптата язвенных краев применяется редко.
- Инструментальные методы. С целью дифференциальной диагностики выполняется рентгенография, компьютерная или магнитно-резонансная томография органов грудной клетки. По показаниям назначается УЗИ мочевого пузыря, мошонки, почек, брюшной полости, малого таза, мягких тканей и лимфатических узлов. В некоторых случаях рекомендованы кольпоскопия, колоноскопия, биопсия пораженных тканей, ирригоскопия.
Дифференциальная диагностика
Дифференциальная диагностика шанкроида проводится со следующими патологиями:
- первичным сифилисом (твердый шанкр безболезненный);
- генитальным герпесом, при котором образуются пузырьки и эрозии;
- острой язвой вульвы Чапина-Липщюца, сопровождающейся выраженной лихорадкой, интоксикацией, множественными язвами на малых половых губах без увеличения лимфоузлов;
- туберкулезом кожи, где элементы безболезненны и могут находиться на лице, туловище, сопровождаться лимфаденопатией.
Лечение шанкроида
Лечение осуществляется в амбулаторных условиях, при осложнениях, требующих хирургического вмешательства, либо декомпенсации хронических болезней, показана госпитализация. Назначается общий режим, при выраженных болях - постельный. Диетические рекомендации сводятся к ограничению жирной, жареной пищи, алкоголя, увеличению водной нагрузки при отсутствии противопоказаний. Необходимо неукоснительное соблюдение правил гигиены.
Консервативная терапия
Лечение при шанкроиде обычно не превышает 3-7 дней. Поскольку нередко возникают одномоментное инфицирование другими заболеваниями, передающимися половым путем, в схему лечения входят препараты широкого спектра действия. Половые партнеры также получают терапевтические средства, если сексуальные контакты были менее чем за 10 дней до появления шанкра. Рекомендуется отказ от половой жизни на время лечения. Терапия представляет собой сочетание:
- Этиотропного лечения. Антибактериальными средствами, активными в отношении возбудителя шанкроида, считаются препараты группы цефалоспоринов и макролидов (первая линия), либо фторхинолоны. Однако эритромицин рекомендуется применять с осторожностью из-за токсических эффектов.
- Патогенетических мер. Дезинтоксикационные инфузионные растворы, глюкокортикостероиды применяются в случае выраженной интоксикации, отека. Могут назначаться аппликации с ферментосодержащими мазями, при длительном торпидном течении - провокация пирогенами.
- Симптоматической терапии. Сюда входят обезболивающие, седативные, десенсибилизирующие и другие средства. В случае присоединения грибкового или вирусного агента применяют соответствующие препараты, при обострении хронических патологий купируют их симптомы.
Местное лечение
Наружная терапия необходима для уменьшения болевых ощущений, также применение антибактериальных мазей ускоряет излечение. Чаще всего в виде примочек используются хлоргексидина биглюконат, низкоконцентрированный раствор димексида. В некоторых ситуациях разрешены теплые ванночки с калия перманганатом (1:5000), а также гелий-неоновый лазер для быстрого рассасывания инфильтрата, предупреждения грубого рубцевания.
Российские рекомендации иногда включают в себя методы физиотерапии, направленные в основном на улучшение местного кровотока, стимуляцию клеточного звена иммунитета. Лечение проводится при отсутствии лихорадки. К таким процедурам относятся микроволновая терапия, индуктотермия, лазеролечение. Применение иммуностимуляторов и адаптогенов в лечении симптомов шанкроида сомнительно и не имеет доказанной эффективности.
Хирургическое лечение
У 40-50% пациентов с шанкроидом в конце первого месяца болезни возникают симптомы гнойного лимфаденита. Абсцедирующие лимфоузлы вскрывают с последующей установкой дренажей либо аспирируют шприцом. При фимозе иссекают отечную крайнюю плоть с удалением гнойных масс. Некротизирующие поражения, вызванные возбудителем шанкроида, подвергаются некрэктомии, в запущенных случаях - ампутации.
Экспериментальное лечение
Исследования действия эфирных масел корицы, тимьяна и гвоздики на возбудителей шанкроида in vitro позволили выявить мощный бактерицидный эффект этих растений. Ученые считают масла перспективной альтернативой антибиотикам в связи с их низкой цитотоксичностью, отсутствием негативного действия на микрофлору, в частности, лактобациллы, растущей антибиотикорезистентностью микроорганизмов.
Прогноз и профилактика
При своевременном выявлении и лечении шанкроида прогноз заболевания благоприятный. Специфическая профилактика (вакцинация) находится в стадии активной разработки. Неспецифическими мерами защиты являются: наличие постоянного полового партнера, отказ от случайных половых связей, использование презерватива, соблюдение правил личной гигиены. Врачам следует пользоваться одноразовыми перчатками при осмотре пациентов с симптомами шанкроида.
1. Эрозивно-язвенные поражения половых органов и промежности/ О.В. Панкратов, В.Г. Панкратов// Журнал «Здравоохранение» - № 3. - 2012.
3. 2017 European guideline for the management of chancroid / S. Lautenschlager, M. Kemp, J. J. Christensen, M. V. Mayans, H. Moi
4. Assessing the antibiotic potential of essential oils against Haemophilus ducreyi/ Z. Lindeman, M. Waggoner, A. Batdorff, T. L. Humphreys
Шанкр мягкий - симптомы и лечение
Что такое шанкр мягкий? Причины возникновения, диагностику и методы лечения разберем в статье доктора Агапова Сергея Анатольевича, венеролога со стажем в 39 лет.
Над статьей доктора Агапова Сергея Анатольевича работали литературный редактор Маргарита Тихонова , научный редактор Сергей Федосов
Определение болезни. Причины заболевания
Мягкий шанкр (венерическая язва, третья венерическая болезнь или шанкроид) — эпидемическое инфекционное заболевание, вызванное стрептобациллой Дюкрея — Петерсена (Haemophilus ducreyi) и передаваемое преимущественно половым путём.

По оценкам ВОЗ (Всемирной организации здравоохранения), до 2001 года ежегодно регистрировалось более семи миллионов случаев мягкого шанкра [1] , однако из-за трудностей диагностики, вероятно, эти цифры были занижены. Наибольшая заболеваемость наблюдалась в странах Юго-Восточной Азии, Африки, Центральной и Южной Америки.

Спорадические (нерегулярные) случаи отмечались в странах Северной Америки, Европы и Австралии. Они были связаны с заражением туристов из указанных стран в эндемичных районах. Однако, после внедрения рекомендаций ВОЗ по синдромному лечению генитальных язв в 2001 году [2] заболеваемость мягким шанкром стала резко уменьшаться.
Причиной заболевания является инфицирование стрептобациллой Дюкрея — Унны — Петерсона (Haemophilus ducreyi). Это анаэробная гемофильная грамотрицательная бактерия, обычно палочкообразной формы, располагающаяся в виде цепочек из 5-30 микроорганизмов, напоминающих «стаю рыб». [5] Бактерии жизнеспособны в гное, слизи и каплях крови в течение нескольких часов.

- случайные половые связи;
- незащищенный презервативом половой акт;
- длинная крайняя плоть; [6]
- воспалительные заболевания кожи, травмы, приём лекарственных препаратов, вызывающих аллергические реакции в области гениталий; [7]
- сопутствующие половые инфекции (ВИЧ, генитальный герпес, сифилис); [8]
- незащищённый контакт кожи с язвами. [9]
Группы риска составляют: [10]
- гомосексуалисты;
- коммерческий секс;
- дети;
- беременные;
- женщины после удаления матки.
Пути передачи инфекции:
- половой контакт, включая анальный [11] и оральный [12] секс;
- контактно-бытовой — сообщается о случаях внеполового заражения, проявляющегося кожными язвами на конечностях у детей [13] и взрослых [14] .
При обнаружении схожих симптомов проконсультируйтесь у врача. Не занимайтесь самолечением - это опасно для вашего здоровья!
Симптомы мягкого шанкра
Болезнь чаще встречается у мужчин, чем у женщин. В некоторых странах соотношение женщин и мужчин колеблется от 3:1 до 25:1. [3] Большинство женщин не имеют клинических симптомов и являются резервуаром инфекции. [15]
Мягкий шанкр
Основным симптомом является шанкр [16] — одиночная или множественные язвы округлой или неправильной формы диаметром 2-3 см с узким эритематозным ободком по периферии. Края язвы подрытые, мягкие, нависающие. Дно язвы часто неровное и покрыто некротическим неприятно пахнущим экссудатом серого или жёлтого цвета. При пальпации основание язвы мягкое, отмечается резкая болезненность.
Локализация у мужчин:
- крайняя плоть;
- головка полового члена;
- уздечка;
- венечная борозда;
- ствол полового члена и мошонка.

Локализация у женщин:
- большие и малые половые губы;
- преддверие влагалища;
- клитор.

Описан случай локализации шанкра во влагалище и шейке матки. [17]
Отсевы появляются в результате аутоинокуляции (случайного переноса микробов) или одновременного инфицирования нескольких участков кожи. Они представляют собой множественные язвы, как правило, небольшого диаметра, зачастую расположенных на соприкасающихся поверхностях или в удалении от основного очага поражения (в области лобка, бёдер, промежности). Являются специфическим симптомом инфекции. [16]

Экстрагенитальные шанкры
Сообщалось о возникновении шанкров на руках, веках, губах, груди, слизистой полости рта, перианальной области и анусе. [16] Но за исключением локализации в области слизистой рта, красной каймы губ и ануса эти случаи, вероятнее всего, являлись результатом аутоинокуляции.
Шанкр, возникающий при анальном контакте, представляет собой резко болезненную небольшую язву, часто линейной формы.

Атипичные шанкры [18]
Карликовый шанкр представляет собой небольшую, поверхностную, относительно безболезненную язву.

Гигантский шанкр — большая гранулематозная язва на месте вскрывшегося пахового бубона, простирающаяся за его пределы.

Фолликулярный шанкроид ассоциирован с волосяными фолликулами больших половых губ и лобка у женщин. Вначале он выглядит как фолликулярная пустула, которая позже трансформируется в классическую язву.
Переходный шанкр представлен в виде поверхностных герпетиформных быстро заживающих язв, но с типичным паховым лимфаденитом.

Серповидный шанкр представляет собой слившиеся между собой множественные язвы, образующие сплошной очаг дуговидной формы.

Фагеденитический шанкр возникает при вторичном инфицировании фузоспирохетами. Изъязвление вызывает обширное разрушение тканей полового члена, вплоть до его самоампутации.

Папулезный (возвышающийся) шанкроид представлен в виде гранулематозной изъязвленной папулы, напоминающей донованоз или широкую кондилому.
Смешанный шанкр возникает при совместном инфицировании бледной трепонемой (возбудителем сифилиса) и стрептобациллами, при котором вначале возникает классическая язва мягкого шанкра, а через 3-4 недели происходит уплотнение ее основания с формированием твёрдого шанкра.

Паховый лимфаденит (бубон)
Развивается в течение 1-2 недель после появления первичной язвы примерно у 30-60% больных, чаще у мужчин.
Паховые лимфатические узлы увеличены с одной стороны и при пальпации болезненные. У четверти больных процесс прогрессирует с образованием гнойного абсцесса c последующим его вскрытием, а также с формированием свищей. [8]

Кожный (внеполовой) шанкроид
Недавние исследования выявили H. ducreyi как ранее непризнанную причину негенитальных кожных язв у детей и у взрослых в тропических районах. [19] Заражение происходит контактно-бытовым путём. Очаги поражения часто представляют одиночную язву в области голеней и бёдер, клинически не отличающуюся видом и течением процесса от классической половой язвы.

Другие поражения
Сообщается о нескольких казуистических (редких) случаях заболеваний, вызванных Haemophilus ducreyi — конъюнктивита [20] и поражения пищевода у ВИЧ-инфицированного пациента [21] .
Патогенез мягкого шанкра
H. ducreyi является строгим патогеном человека. Проникая в кожу или слизистые оболочки через микроповреждения в результате их травмирования, стрептобациллы образуют в тканях внеклеточные микроколонии в виде микропустул.
Лимфоциты и макрофаги быстро окружают возбудителя, но благодаря его вирулентным свойствам, он уклоняется от фагоцитоза (захвата и поглощения) и, следовательно, от уничтожения.
В процессе развития заболевания формируется гранулематозный инфильтрат, заполненный нейтрофилами и фибрином, трансформирующийся в язву [22] .

Исследованиями выявлены следующие вирулентные факторы H. ducreyi:
- адгезины LspA1 и LspA2 — белки, ингибирующие (подавляющие) фагоцитарную активность гранулоцитов и макрофагов; [23]
- белок DsrA — участвует в формировании резистентности (устойчивости) к сывороточному комплементу и связывается с кератиноцитами (основными клетками эпидермиса кожи) человека; [24]
- MOMP — основной белок наружной мембраны, который участвует в формировании резистентности к иммуноглобулинам сыворотки; [25]
- белок теплового шока GroEL — отвечает за присоединение H. ducreyi к углеводным рецепторам; [26]
- фимбриаподобный белок flp — участвует в прикреплении H. ducreyi к фибробластам крайней плоти человека; [27]
- лектин DltA — распознаёт гликозилированные рецепторы на клетках-хозяевах и играет роль в адгезии (прикрепления) H. ducreyi к тканям-хозяевам; [28]
- Липополигосахарид (LOS) — обеспечивает прилипание бактерий к кератиноцитам и фибробластам крайней плоти человека; [29]
- белки OmpP2A и OmpP2B — облегчают получение питательных веществ и обеспечивают стабильность мембраны возбудителя; [30]
- Ftp-гены — помогают в присоединении к клетке-хозяину и необходимы для образования микроколоний H. Ducreyi; [31]
- Cu, Zn-супероксиддисмутаза (Cu, Zn-SOD) — защищает возбудителя от супероксид-анионов; [32]
- цитолептический токсин (CDT) — индуцирует апоптоз (гибель) B-клеток и Т-клеток; [33]
- липопротеин , ассоциированный с пептидогликаном (PAL) — основной липопротеин H. ducreyi, который связывает внешнюю мембрану с пептидогликаном. [33]
Классификация и стадии развития мягкого шанкра
Международная классификация болезней 10-го пересмотра (МКБ-10) относит мягкий шанкр (шанкроид) к классу инфекций, передающихся преимущественно половым путём, и кодирует как A57.
Клиническими наблюдениями и экспериментальной моделью на людях-добровольцах [34] были определены следующие стадии патологического процесса:
- инкубационный (скрытый) период — от 2 до 10 суток;
- эритематозно-папулёная стадия — болезнь начинается с эритематозного пятна, которое в течение 24 часов трансформируется в папулу;
- пустулёзная стадия — папула эволюционирует в пустулу, которая существует в течение 24-72 часов и вскрывается с образованием язвы;
- язвенная стадия — характеризуется существованием стойкого язвенного дефекта в течение 3-4 недель;
- стадия заживления и рубцевания — в среднем она наступает через четыре недели после начала заболевания и продолжается около нескольких недель с образованием плоского рубца.

Осложнения мягкого шанкра
ВИЧ-инфекция
Шанкроид является важным кофактором (необходимым компонентом) передачи ВИЧ-инфекции. В язве мягкого шанкра содержится повышенное количество CD4-позитивных лимфоцитов, вызванное клеточным иммунным ответом на H. ducreyi, которые являются первичными мишенями ВИЧ.
Фактически, шанкроид является распространённой инфекцией во всех 18 странах, где распространённость вируса иммунодефицита взрослого человека превышает 8% населения. Также известно, что нарушение целостности слизистой оболочки является входными воротами вируса, а H. ducreyi увеличивает экспрессию рецептора CCR-5 на макрофагах, тем самым повышая восприимчивость этих клеток к заражению ВИЧ. [35]
Фимоз и парафимоз
Наличие язв в области крайней плоти ведёт к образованию фимоза (сужению крайней плоти с невозможностью открыть головку полового члена) или к парафимозу (ущемлению головки полового члена кольцом суженной крайней плоти). [36]

Свищи
Такие осложнения образуются при вскрытии поражённых паховых лимфатических узлов.

Диагностика мягкого шанкра
Диагноз устанавливают на основании клинического осмотра, анамнеза и результатов лабораторных исследований. Центры по контролю за заболеваемостью (США) рекомендуют следующие критерии для постановки вероятного диагноза мягкого шанкра: [37]
- одна или несколько болезненных генитальных язв;
- болезненные паховые лимфатические узлы;
- отрицательный результат при исследовании экссудата из язвы в тёмном поле или теста амплификации нуклеиновой кислоты (ПЦР) на Treponema pallidum и отрицательный серологический тест на сифилис, проведённый по меньшей мере через семь дней после появления язв;
- отрицательный результат теста амплификации нуклеиновой кислоты (ПЦР) на вирус простого герпеса.
Для диагностики мягкого шанкра применяются следующие лабораторные исследования: [38]
- Бактериоскопический метод, при котором обнаруживаются грамотрицательных стрептобациллы в виде цепочек из 20-30 коротких палочек. Чувствительность колеблется от 5% до 63%, а специфичность — от 51% до 99%. [5]

При диагностике мягкого шанкра рекомендовано одновременное исследование на ВИЧ-инфекцию, сифилис и генитальный герпес. [40]
Дифференциальный диагноз мягкого шанкра проводят с:
- первичным сифилисом;
- генитальным герпесом;
- острой язвой вульвы Липшютца-Чапина;
- донованозом;
- кожным туберкулезом;
- синдромом Бехчета;
- болезнью Крона;
- многоформной экссудативной эритемой;
- плоскоклеточной карциномой.
Лечение мягкого шанкра
Всемирная организация здравоохранения рекомендует в случае наличия генитальных язв, при отсутствии возможностей для лабораторной диагностики, провести синдромное лечение [2] , заключающееся в однократном применении внутримышечного введения 2,4 млн ЕД бензатина бензилпенициллина + перорального приёма 1 г азитромицина.
Исходя из восприимчивости in vitro (в живой среде), наиболее активными препаратами против H. ducreyi являются азитромицин, цефтриаксон, ципрофлоксацин и эритромицин.
Международный союз борьбы с венерическими болезнями (IUSTI) [40] и Центры по контролю заболеваемости (CDC) [37] рекомендуют для лечения мягкого шанкра следующие схемы:
- Первая линия терапии:
- Цефтриаксон — однократная внутримышечная инъекция 250 мг, или
- Азитромицин — однократная пероральная доза 1 г. антибиотика
- Вторая линия терапии:
- Ципрофлоксацин — приём 500 мг перорально 2 раза в день в течение трех дней, или
- Эритромицин — приём 500 мг перорально 4 раза в день в течение семи дней.
Абсцедирующие лимфатические узлы аспирируют иглой или вскрывают с последующим дренированием. [37]

Цефтриаксон может применяется у детей и беременных. Ципрофлоксацин противопоказан беременным и кормящим женщинам, а также детям и подросткам младше 18 лет — в этих случаях следует применять схемы с эритромицином или цефтриаксоном.
При успешном лечении язвы обычно начинают заживать в течение первых трёх дней. Время, необходимое для полного выздоровления, зависит от размера язвы — для больших поражений может потребоваться более двух недель. Даже при вовремя начатом лечении возможно образование рубцов.
Пациенты должны воздерживаться от любого сексуального контакта, пока курс лечения не закончен. Какие-либо контрольные тесты для установления излеченности не требуются. Пациенты должны пройти повторный тест на сифилис и ВИЧ через три месяца после лечения, если ранние результаты тестов были отрицательными.
Сексуальные партнёры больных независимо от наличия симптомов заболевания подлежат обследованию и лечению, если они имели половой контакт с пациентом в течение 10 дней, предшествующих возникновению язв у пациента. [37]
Прогноз. Профилактика
При своевременном выявлении и вовремя начатой адекватной терапии прогноз благоприятный.
Самой эффективной мерой профилактики является использование презерватива при случайных половых контактах, включая оральный и анальный секс. Но следует помнить, что очаги поражения при шанкроиде могут находиться вне зоны защиты презерватива. Поэтому следует избегать любых половых контактов во время туристических поездок с жителями стран, эндемичных по мягкому шанкру.
Твёрдый шанкр от сифилиса

Шанкр является первым и очевидным клиническим признаком заражения сифилисом. Его обнаружение значительно повышает возможность своевременной диагностики, лечения и, как следствие, полного выздоровления. Дело в том, что сифилис - одно из немногих заболеваний, которое можно вылечить буквально несколькими уколами при своевременном обнаружении. Его возбудитель - бледная трепонема - плохо приспосабливается к антибиотикам и до сих пор не потеряла чувствительности к пенициллину! Вот почему важно знать, как выглядит шанкр, каких видов бывает и как отличить сифилитический шанкр от не сифилитического.
Виды шанкра
Шанкр - это изъязвление, возникающее через 3-90 (в среднем - 21) дней с момента заражения сифилисом, чаще - в зоне проникновения возбудителя в организм пациента. Сначала на коже образуется розовое пятно (воспаление), затем на этом месте возникает плотный узелок, через 7-10 дней он некротизируется и превращается в язву или эрозию. Если образовавшийся шанкр не сопровождается зудом или болью, то его называют сифиломой.
Сифилома имеет правильную округлую или овальную форму и четкие границы, которые выступают над кожей. Края плотные, валикообразные. Дно сифиломы красное, реже - мясного цвета, может быть красно-бурое, а сам шанкр выглядит лакированным, из-за особенностей раны.
Размеры сифиломы варьируются от 5 до 30 мм, но встречаются язвы большего или меньшего диаметра. Основной признак твердого шанкра - хрящеватое уплотнение в основании язвы, которое прощупывается при пальпации. При надавливании шанкр безболезнен. Кожа вокруг язвы чистая, без признаков воспаления.
Шанкр формируется вследствие проникновения в организм бледной трепонемы (спирохеты). Для размножения ей подходит температура человеческого тела и после попадания в организм она активно образует сифиломы. Сами же шанкры могут быть разных видов, форм и размеров.
Классификация
По количественному признаку
Единичный — шанкр в виде отдельного новообразования, или множественный, который выглядит как несколько изъязвлений.
По происхождению
Шанкры-близнецы - возникают при одновременном заражении - когда возбудитель попадает в организм пациента не в одном, а в нескольких «местах». То есть вместо одного шанкра можно обнаружить два и более.
Шанкры, образовавшиеся вследствие заражения в разное время. Появляются один за другим, примерно в одном и том же месте.
Так называемый «целующийся» шанкр, который возникает на соприкасающихся поверхностях.
Формированию множественных сифилом могут способствовать сопутствующие заболевания:
- чесотка
- угревая сыпь
- травмы кожных покровов
По глубине проникновения в ткани
Сифиломы имеют разную глубину поражения тканей.
Язвенные поражают глубокие слои кожи. Могут насквозь проходить дерму - вплоть до подкожной клетчатки. Имею шероховатое, покрытое гнойным налетом дно. Эрозии располагаются ближе к поверхности. Дно гладкое, блестящее, по форме напоминает блюдце.
По размеру
Кроме стандартных размеров от 5 до 10 мм, встречаются гигантские и карликовые шанкры.
Гигантские шанкры чрезвычайно редки, могут достигать до 20 см в диаметре. Локализуются, в основном, в областях скопления жировой клетчатки: на животе, бедрах, лобке. Карликовыми называют сифиломы размером с маковое зёрнышко - 1-2 мм, рассмотреть их можно только через лупу. Встречаются редко.
По расположению
Шанкр может располагаться на разных частях тела:
- генитальные сифиломы располагаются на половых органах
- экстрагенетальные - на любых других участках тела вне гениталий (рис.1)
- биполярные сифиломы возникают одновременно и на гениталиях, и за пределами промежности.
По форме
Кроме классической округлой формы, шанкр может иметь иной вид.
Щелевидные сифиломы похожи на трещины. Они могут образоваться в углах рта, на языке, возле ануса. Встречаются редко. Располагаясь в углах рта, могут восприниматься обладателем, как неопасные «заеды».
Корковый шанкр не похож на обычные сифиломы, он не вогнутой формы и покрыт коркой. Обычно она образуется на язвах, которые располагаются в местах, где их содержимое легко высыхает: поверхность носа, лицо, углы рта.
Дифтеритический шанкр покрыт пленкой пепельно-серого цвета, похожей на дифтерийную. Встречается достаточно часто. Локализоваться может в любой области.
Ожоговый шанкр быстро увеличивается в диаметре, при этом его границы теряют правильную форму и четкие очертания, а дно из гладкого становится красно-зернистым (рис. 2). Обычно первичные сифиломы не имеют тенденции к росту. Это - исключение.
Эрозивный шанкр включает множество эрозий, язвочки могут сливаться. Образуется исключительно на слизистых оболочках гениталий.
Герпетиформный шанкр назван так за сходство с генитальным герпесом. Это эрозивное образование, в поле которого находится множество мелких язв с четко выраженными краями. Похож на баланит Фольмана, но в данном случае язвочки не сливаются.
Локализация
Так как сифилис передается преимущественно половым путем, твердый шанкр чаще всего локализуется на гениталиях. Однако клиническая практика показывает, что сифиломы почти так же часто обнаруживаются во рту и в области ануса.
Это значит, что шанкр может появиться где угодно, местом его локализации могут быть:
- половой член и мошонка
- половые губы и клитор
- задняя спайка и область ануса
- лобок
- ротовая полость: губы, десны, язык и горло
- внутренняя поверхность бедер
- грудь и живот
- лицо
- редко - веки, конъюнктива глаз
Шанкр может располагаться внутри половых органов, например, на стенках влагалища или шейке матки, тогда сифилому обнаружить сложно.
Стадии развития
Инкубационный период
Инкубационный период - от момента заражения до появления симптомов болезни - длится в среднем от 2-х недель до 2-х месяцев, хотя известны наблюдения большей продолжительности. Все зависит от состояния иммунитета на момент заражения. Длительные бессимптомные периоды обычно встречаются у людей, которые принимали в момент заражения антибактериальные препараты для лечения других заболеваний.
Во время инкубационного периода бледные трепонемы размножаются в лимфатической системе, пока не достигнут максимальной концентрации. Затем проникают в кровоток и распространяются по организму. В это время болезнь никак не проявляется и не определяется в анализах крови, но человек уже заражен. Не догадываясь об этом, он или она подвергают опасности полового партнера, если практикуют незащищенный секс.
Важно! Бледная трепонема может размножаться в малом диапазоне температур, около 37 °C. Поэтому для лечения сифилиса практикуют метод пиротерапии - повышения температуры тела. Больному вводят препараты, повышающие температуру тела, в результате чего трепонема лишается возможности размножаться. Такой метод считается наиболее действенным при неспецифическом лечении сифилиса.
Образование шанкра

Рисунок 3. Развитие сифиломы. Источник: СС0 Public Domain
Попав в мягкие ткани, трепонема начинает активно размножаться. В этот период не исключено незначительное повышение температуры, увеличение близлежащих лимфоузлов, которые можно прощупать. В месте заражения развивается воспаление - так иммунные клетки пытаются уничтожить врага.
Снаружи очаг воспаления выглядит как ярко-розовый участок кожи. Затем на коже образуется характерный плотный узелок - зачаток будущего шанкра (рис. 3). Он увеличивается, уплотняется и через неделю-полторы изъязвляется.
Если язва покрывается коркой, то шанкр называется также -корковым. Если надавить на неё, то выступит желтоватая жидкость, в которой присутствует высокая концентрация трепонем. Такую сифилому называют «плачущим шанкром».
Выделения из твердого шанкра заразны, при соприкосновении с ними возможна передача инфекции. Особенно высока эта опасность при расположении твердого шанкра во рту - велик риск заражения партнера сифилисом даже через поцелуй.
Образование шанкра свидетельствует о завершении инкубационного периода и наступлению первичной стадии сифилиса . Шанкр не тревожит носителя ни зудом, ни болью, что плохо - человек может попросту не обратить на него внимания и упустить время.
Заживление шанкра
Изъязвленный шанкр существует 6-7 недель, затем начинается заживление. Эрозия может пройти бесследно, но иногда оставляет тёмное пигментное пятно. При заживлении язвы остается рубец. За несколько дней до исчезновения шанкра на теле могут появиться обильные зудящие высыпания.
На этом этапе сифилис переходит во вторичную стадию.
Важно! Заживление твердого шанкра часто принимают за выздоровление. Это не так. На самом деле болезнь продолжает развиваться, распространяясь по всему организму.
Чем отличается мягкий шанкр от твердого
Существует похожий на твердый - мягкий шанкр (шанкроид). Он также, как и сифилис, передается половым путем, но возникает вследствие инфицирования не бледной трепонемой, а бактериями рода гемофил.
Шанкроид отличается от твердого шанкра следующими признаками:
- отсутствует твердое хрящеватое основание (поэтому шанкроид и называют «мягким»)
- края язвы не твердые, а мягкие, расползающиеся
- характерно обильное выделение гноя
- болезненный
- цвет ярко-розовый, красный
Для выявления сифилиса используется несколько основных методик:
- Обнаружение бледной трепонемы с помощью микроскопа в соскобе, взятом из шанкра.
- Серологический метод (реакция Вассермана) - когда определяют специфические белки, которые вырабатывает иммунная система в ответ на появление в организме трепонем, при первичном сифилисе не эффективен.
- Реакция микропреципитации - экспресс-диагностика, основанная также на выработке организмом антител.
- Специфичные тесты РИФ, РИТ, РПГА и т.д. - сложны для постановки, трудоемки и дороги. Применяют для выявления скрытого сифилиса, в сложных нетипичных случаях, при дифференциальной диагностике и для диагностики позднего сифилиса.
Если трепонему обнаружили сразу с помощью микроскопии, дополнительных исследований для доказательства заражения не требуется. По обнаружению трепонемы лечение назначают немедленно.
Иногда требуется провести целый комплекс диагностических мероприятий, чтобы установить точный диагноз, поэтому самостоятельно диагностировать заболевание невозможно, необходимо обратиться к врачу.
Лечение
Следует отметить: в запущенных случаях, когда не удается избавиться от шанкра, а также при обширном некрозе тканей, прибегают к хирургическому удалению сифиломы.
Во всех остальных случаях сам шанкр не обрабатывают и специфического лечения неосложненного шанкра не проводят. При вторичных и сочетанных инфекциях могут назначать антибактериальные препараты местного применения: ванночки с бензилпенициллином и димексидом, аппликации с ртутной или ртутно-висмутовой мазью. При расположении шанкра в ротовой полости рекомендованы полоскания: раствор фурацилина, борной кислоты (2%), или грамицидина (2%).
Основная же задача состоит в избавлении от сифилиса максимально быстро и с минимальными потерями. Поэтому для лечения сифилиса используют антибиотики пенициллинового ряда - короткие и пролонгированные (дюрантные) пенициллины: Бициллин-1, Бициллин-5, Оксациллин, Ампициллин (полусинтетический пенициллин). Препаратом выбора для лечения сифилиса является бензилпенициллин.
Препараты резерва при непереносимости пенициллина: тетрациклины (доксициклин), макролиды (азитромицин, эритромицин), цефалоспорины (цефтриаксон).
Введение лекарств инъекционное - внутривенное или внутримышечное.

Источник: СС0 Public Domain
Схема лечения зависит от стадии заболевания, локализации, степени поражения и т.д. В любом случае доза лекарственного вещества и количество курсов лечения рассчитывается врачом индивидуально.
В процессе лечения проводят контрольные анализы, чтобы получить подтверждение эффективности препаратов.
Лечение сифилиса на ранней стадии является наиболее эффективным и создает все предпосылки для полного излечения без последствий и осложнений.
Рекомендации на период лечения
В период лечения необходимо прекратить половые контакты. При локализации шанкра на пальцах рекомендуется носить защитные перчатки. Если сифилома обнаружена во рту, надо отделить предметы индивидуального пользования от общих - посуду, зубные щетки и т.д.
При наличие шанкров на теле пользование постельным бельем, полотенцем, мочалкой должно быть индивидуальным. Через места общего пользования (туалет и т.д.) сифилис не передается.
Половые партнеры заболевших получают превентивное лечение в обязательном порядке, в том числе беременные и кормящие.
Важно! Следует обязательно закончить полный курс лечения! Ни при каких условиях сифилис не исчезнет самопроизвольно. Недолеченный сифилис перейдет в следующую стадию, повышая риск осложнений и стойкого ухудшения состояния заболевшего.
Клинико-серологический контроль (КСК)
Всем членам семьи заболевшего, как взрослым, так и детям необходимо получить превентивное лечение после полового или тесного бытового контакта с больными ранними формами сифилиса. Через 3 месяца после окончания превентивного лечения проводят однократное клинико-серологическое обследование.
Клинико-серологический контроль (КСК) после окончания специфического лечения больного осуществляют 1 раз в 3 месяца в течение первого года наблюдения. Далее 1 раз в 6 месяцев в последующие годы с постановкой нетрепонемных (простых серологических) тестов, 1 раз в год - с постановкой соответствующего трепонемного теста (сложный тест для выявления возможных скрытых форм сифилиса), который использовался при диагностике заболевания. Длительность КСК определяется индивидуально в зависимости от результатов лечения.
Дети, родившиеся от серопозитивных матерей, но не болевшие врожденным сифилисом, вне зависимости от того, получали они профилактическое лечение или нет, подлежат наблюдению в течение 1 года. Дети, получающие специфическое лечение, состоят на КСК в течение 3 лет.
Профилактика
Так как путь передачи заболевания в основном половой, превентивные меры заключаются в соблюдении верности половых партнеров - это самая действенная профилактика венерических заболеваний. При сексуальных контактах с непроверенным человеком всегда надо пользоваться презервативом.
Барьерная контрацепция (презерватив) дает практически 100% защиты от заражения сифилисом.
В любом случае после случайного контакта необходимо самостоятельно обработать генитальную область антисептическими средствами: мирамистином или хлоргексидином.
Если же незапланированный контакт произошел без средств защиты, или нарушилась целостность презерватива в процессе, врачи рекомендуют в течение самого ближайшего времени посетить КВД и сделать профилактическую инъекцию, которая практически на 100% предотвратит развитие сифилиса.
Заключение
Твердый шанкр - это основной симптом первичной стадии сифилиса. Если вовремя обратиться к врачу, можно быстро вылечиться без последствий для организма. При обнаружении подозрительной язвочки не стоит ждать, когда она заживет, лучше показаться специалисту и сдать необходимые анализы. Это поможет исключить, а в случае необходимости, обезвредить жестокую инфекцию, которая, получив развитие, приведет к поражению всего организма.
Читайте также:
- Исследование физиологических пассивных движений плечевого сустава
- Прочие иммунобиологические препараты. Фаги. Бактериофаги. Классификация фагов. Приминение бактериофагов.
- Синдром Бонхеффера (Bonhoeffer)
- Расширенные периваскулярные пространства головного мозга на МРТ
- КТ при врожденных заболеваниях семенных пузырьков
